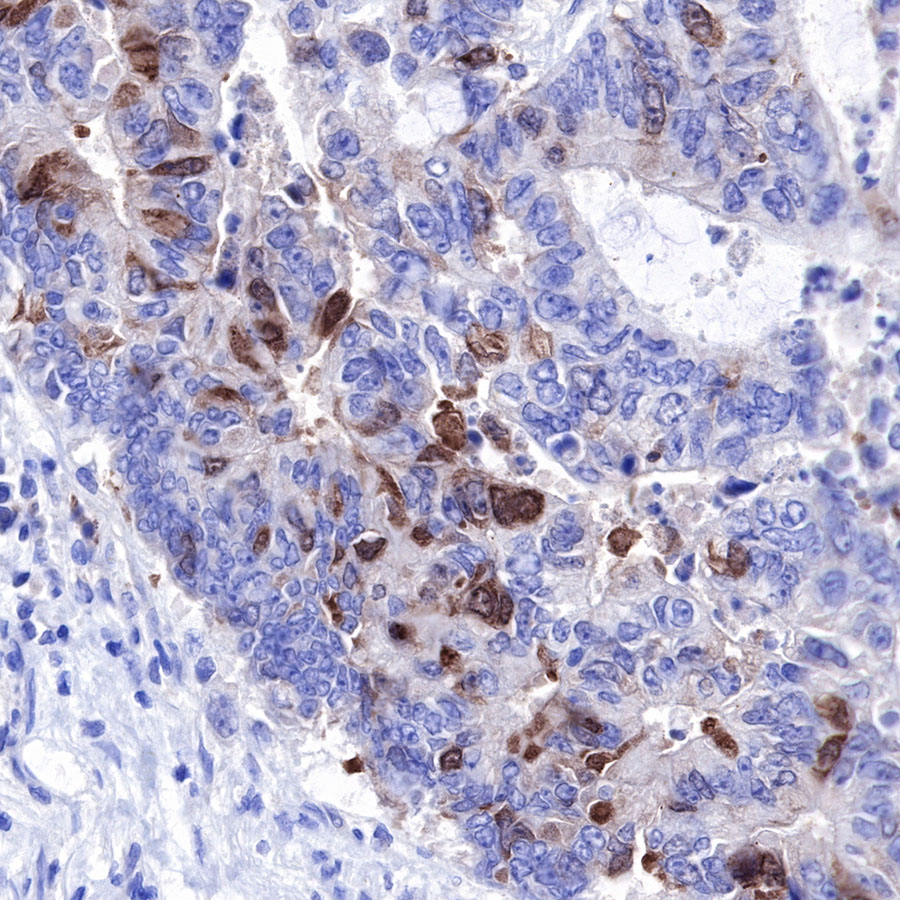

WB result of PLK1 Rabbit mAb
Primary antibody: PLK1 Rabbit mAb at 1/20000 dilution
Lane 1: HeLa whole cell lysate 20 µg
Lane 2: K-562 whole cell lysate 20 µg
Lane 3: HepG2 whole cell lysate 20 µg
Secondary antibody: Goat Anti-Rabbit IgG, (H+L), HRP conjugated at 1/10000 dilution
Predicted MW: 68 kDa
Observed MW: 62 kDa
Product Details
Product Details
Product Specification
| Host | Rabbit |
| Antigen | PLK1 |
| Synonyms | STPK13 |
| Immunogen | N/A |
| Location | Nucleus |
| Accession | P53350 |
| Clone Number | SDT-R062 |
| Antibody Type | Rabbit mAb |
| Application | WB, IHC-P, IP |
| Reactivity | Hu |
| Purification | Protein A |
| Concentration | 1.0 mg/ml |
| Physical Appearance | Liquid |
| Storage Buffer | PBS, 40% Glycerol, 0.05%BSA, 0.03% Proclin 300 |
| Stability & Storage | 12 months from date of receipt / reconstitution, -20 °C as supplied |
Dilution
| application | dilution | species |
| IHC-P | 1:200 | null |
| WB | 1:20000 | null |
| IP | 1:100 | null |
Background
PLK1 is a serine/threonine kinase that plays a pivotal role in cell division. Its dysregulation is tightly linked to malignant transformation. In human cancers, there is growing evidence coupling PLK1 activity to tumor development, progression, and therapy resistance. PLK1 is overexpressed in various cancers, and its expression levels correlate with poor prognosis. During cell division, the most prominent network or chestrating mitotic onset consists of the PLK1-Aurora A-Cyclin B1/CDK1 feedback loop. In this respect, PLK1 activity is reported to be a critical prerequisite for mitotic entry.
Picture
Picture
Western Blot

IP

PLK1 Rabbit mAb at 1/100 dilution (1µg) immunoprecipitating PLK1 in 0.4mg K562 whole cell lysate.
Western blot was performed on the immunoprecipitate using PLK1 Rabbit mAb at 1/1000 dilution.
Secondary antibody (HRP) for IP was used at 1/400 dilution.
Lane 1 : K562 whole cell lysate 10µg(input)
Lane 2 : PLK1 Rabbit mAb IP in K562 whole cell lysate
Lane 3 : Rabbit monoclonal IgG IP in K562 whole cell lysate
Predicted MW: 68 kDa
Observed MW: 62 kDa
Immunohistochemistry

IHC shows positive staining in paraffin-embedded human tonsil. Anti-PLK1 antibody was used at 1/200 dilution, followed by a HRP Polymer for Mouse & Rabbit IgG (ready to use). Counterstained with hematoxylin. Heat mediated antigen retrieval with Tris/EDTA buffer pH9.0 was performed before commencing with IHC staining protocol.
IHC shows positive staining in paraffin-embedded human colon cancer. Anti-PLK1 antibody was used at 1/200 dilution, followed by a HRP Polymer for Mouse & Rabbit IgG (ready to use). Counterstained with hematoxylin. Heat mediated antigen retrieval with Tris/EDTA buffer pH9.0 was performed before commencing with IHC staining protocol.

IHC shows positive staining in paraffin-embedded human colon cancer. Anti-PLK1 antibody was used at 1/200 dilution, followed by a HRP Polymer for Mouse & Rabbit IgG (ready to use). Counterstained with hematoxylin. Heat mediated antigen retrieval with Tris/EDTA buffer pH9.0 was performed before commencing with IHC staining protocol.

IHC shows positive staining in paraffin-embedded human lung squamous cell carcinoma. Anti-PLK1 antibody was used at 1/200 dilution, followed by a HRP Polymer for Mouse & Rabbit IgG (ready to use). Counterstained with hematoxylin. Heat mediated antigen retrieval with Tris/EDTA buffer pH9.0 was performed before commencing with IHC staining protocol.
